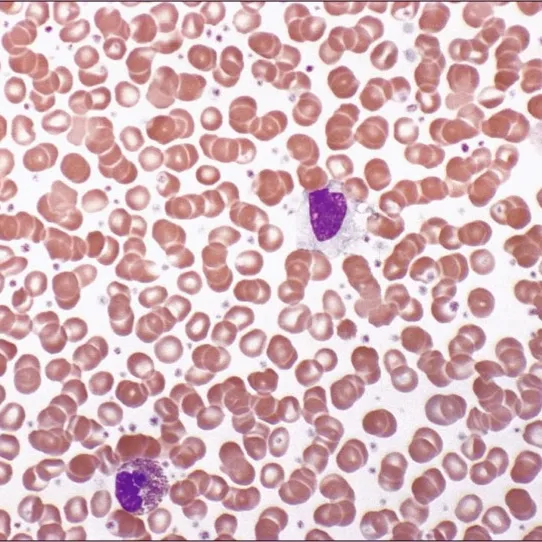
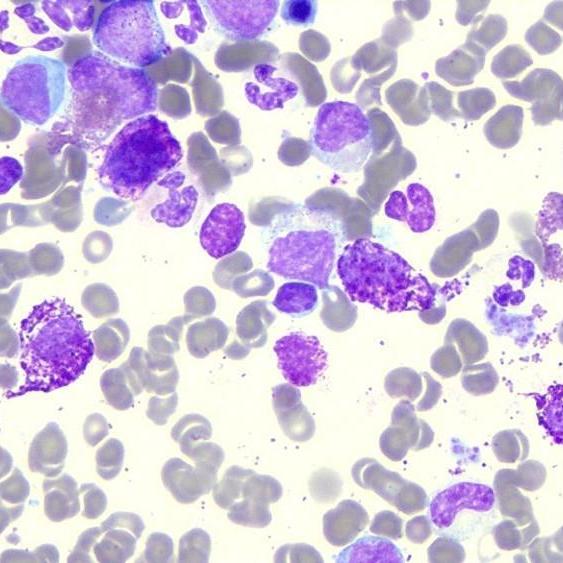

Clinical trials are research studies conducted to evaluate the safety, effectiveness, and side effects of new medical treatments, drugs, or procedures. In the domains of oncology and hematology, these trials are crucial for advancing our understanding and treatment of various cancers and blood disorders. They are meticulously designed and regulated studies that involve human participants, often progressing through several phases. Each phase has distinct goals, ranging from assessing safety and dosage (Phase I) to comparing the new treatment with the standard of care (Phase III). These trials provide critical data that can lead to the approval of new therapies by regulatory bodies, ensuring that patients receive treatments that have been thoroughly tested.
The importance of clinical trials in oncology and hematology cannot be overstated. These trials are the primary method by which new cancer treatments are developed, tested, and brought to market. They help identify the most effective therapies for specific types of cancer and blood disorders, considering factors like genetic mutations, disease stage, and patient health. By participating in clinical trials, patients gain access to cutting-edge treatments that are not yet widely available, offering hope when standard treatments have failed. Furthermore, clinical trials contribute to the accumulation of scientific knowledge, helping to refine existing therapies and develop new ones.
Initiated by the discovery of the JAK2 mutation, the past decade has seen a great deal of activity in the development of potential new therapies for MPNs. Several JAK inhibitor drugs are in clinical trials as well as other therapy types such as stem cell transplant.
In addition to their direct impact on patient care, clinical trials play a vital role in the broader medical community. They help establish new standards of care, guide clinical practice, and inform healthcare policy. The data generated from these trials also support the development of guidelines and recommendations by professional organizations, ensuring that patients receive the most effective and up-to-date treatments. Moreover, clinical trials in oncology and hematology often involve collaborations between researchers, pharmaceutical companies, and healthcare providers, fostering innovation and accelerating the pace of medical advancements. Through these collaborative efforts, clinical trials help bridge the gap between laboratory research and clinical application, ultimately improving patient outcomes and advancing the field of medicine.
The decision to take part in a clinical trial is a personal one and should be made with the input of your physician. Clinical trials can provide access to new medications that may be of benefit for treatment of your disease, and the data from clinical trials is of great benefit in helping future patients affected with similar condition. But you also need to consider that these medications are usually experimental and some of the adverse effects may not be known. Participating in a clinical trial may mean a time commitment, with more frequent visits to the trial centre.